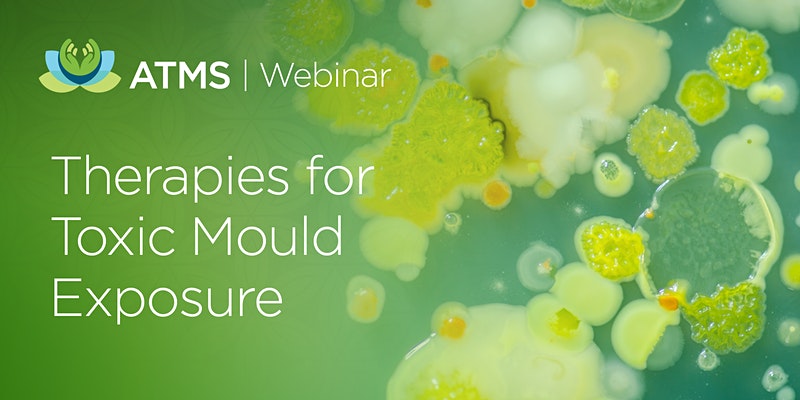
Dr. Crista

Upcoming Events and Conference
Past Events

Integrative Healthcare Symposium

LymeBytes! Symposium

ISEAI 2025 Fall Symposium

A4M Pediatric Symposium

PedANP Annual Conference

2025 Taiwan Symposium
April 2025
Taipei, Taiwan

Medical Academy of Pediatrics and Special NeedsSpring Conference
March 2025
Myrtle Beach, SC

Integrative Medicine for Mental Health 2024
October 2024
Washington, DC

A4M The Future Of Pediatric Medicine
September 2024
Los Angeles, CA

Cellular Detoxification Conference
International College of Integrative Medicine
September 2024
Indianapolis, IN

Advanced Applications In Medical Practice
May 2024
Scottsdale, AZ

The Forum For Integrative Medicine
February/March 2024
Austin, TX

The University of Arizona Andrew Weil Center for Integrative Medicine Fellowship Immersion Week
January 2024
Tucson, AZ

A4M Pediatric Immune Health Summit
October 2023

Toxin Exposure: Diagnosis and Treatment
RealTime Labs
July 2023

Integrative & Personalised Medicine 2023
June/July 2023

National University Of Health Sciences Integrative Health Conference 2023
June 2023

The Forum For Integrative Medicine 2023
March 2023

Academy of Integrative Health & Medicine
October 2022

Montana Association of Naturopathic Physicians Conference
October 2022

National University of Natural Medicine Autoimmune Disorders Conference
June 2022

International IV Nutritional Therapy
April 2022

OANP Annual Pharmacy and Ethics Conference
November 2021

Academy of Integrative Health & Medicine
October 2021

Midwest Integrative Summit
October 2021

GastroANP Annual Conference 2021
October 2021

Mold, The Invisible Hurdle
June 2021

Medicines from the Earth Herb Symposium 2021
June 2021

Environmental Toxin Summit
April 2021

Become A Bilophile?
April 2021

A Comprehensive & Practical Review of Mold Toxicity and its Complications
April 2021

European Mycotoxin Summit
April 2021

Medical Academy of Pediatric Special Needs Conference
March 2021

International Lyme and Associated Diseases Society Seminar
February 2021
Australian Traditional Medicine Society Webinar
February 2021

International IV Nutritional Therapy Seminar
February 2021

Nova Scotia Naturopathic Conference
October 2020

Advanced Applications In Medical Practice
October 2020

Washington Association ofNaturopathic Physicians
October 2020

Case Studies In Mold Exposure andTreatment Protocols
June 2020

The Forum For Integrated Medicine 2020
March 2020

California Naturopathic Doctors Association 2020 Conference
February 2020

Environmental Toxin Summit
November 2019

International Lyme andAssociated Diseases Society
November 2019

A Bear of a Problem: Brain on Fire
April 2019
Hawaii Doc Talks Conference
January 2019

International Lyme andAssociated Diseases Society
November 2018

Pennsylvania Association ofNaturopathic Physicians
October 2018

International Lyme and Associated Diseases Society
November 2017

Academy of Integrative Health & Medicine
October 2017

American Association of Naturopathic Physicians
July 2017

Academy of Integrative Health & Medicine
November 2016

Wisconsin Naturopathic Doctors Association
March 2016





